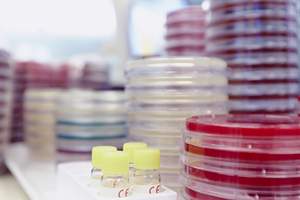

Die Erweiterung der Laborkapazitäten im eigenen Haus ermöglicht eine zeitnahe Diagnose von COVID-19-Infektionen. Zudem werden die Bremer Labore entlastet, in denen die Testungen aus Praxen und den anderen Krankenhäusern bearbeitet werden. „Wir sind sehr stolz darauf, diesen zur Zeit so wichtigen diagnostischen Baustein für die Erregerdiagnostik an sieben Tagen in der Woche anbieten zu können“, so Institutsleiter Dr. Bernd Wolters. „Damit ist das St. Joseph-Stift das erste Krankenhauslabor im Land Bremen und umzu, welches diese Diagnostik durchführen kann.“
Den Mitarbeitern des Instituts ist es in sehr kurzer Zeit gelungen, einen spezifischen Nachweis des SARS-CoV-2 Erregers zu etablieren, der auch bereits für den Einsatz in Europa zugelassen wurden. Für den molekulargenetischen Nachweis von Erregern hat die Schwachhauser Klinik vor zwei Jahren die Technik für derartige Erregernachweise eingeführt. Bisher wurde dies für den Nachweis anderer wichtiger Erreger, wie z.B. die hochkontagiösen Durchfall verursachenden Noroviren und die gefährlichen echten Grippeviren (Influenza) eingesetzt.
Der neue Test kann in einem gemeinsamen Ansatz die ebenfalls wichtigen Viren Influenza A und B sowie das Respiratory-Synthycial Virus (RSV) nachweisen. Damit können bei Erkrankten die wichtigsten differentialdiagnostischen Erreger sofort nachgewiesen oder ausgeschlossen werden. Torsten Jarchow, Geschäftsführer der Klinik ergänzt: „Aufgrund der weltweit angespannten Lage bei der Lieferung von Reagenzien kann unser Labor zur Zeit nur eine begrenzte Anzahl von Tests durchführen und setzt diese ausschließlich für erkrankte Patienten unseres Hauses mit COVID-19 ein.“